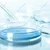
SBT Instruments Borosilicate Glass 5pcs Petri Dishes Set, 150mm Diameter for Microbiology Experiments

- Farm & Garden
- Pumps & Motors
- Food Processing
- Workshop, DIY & MRO
- Lab & Measuring Tools

Brand: SBT Instruments
SBT Instruments Borosilicate Glass 5pcs Petri Dishes Set, 150mm Diameter for Microbiology Experiments
SKU: TB-SB-48230
Estimated Delivery By: Jul 11 - Jul 13 




MRP : ₹4999 ₹2780
44% OFF!
Estimated Delivery By: Jul 11 - Jul 13 
Easy Return
& Refund
& Refund

Quality
Assurance
Assurance

Trusted
Delivery
Delivery

After Sales
Assistance
Assistance

Buyer
Protection
Protection
₹2780 (Including GST)
MRP : ₹4999
44% OFF!
Get Extra ₹42 OFF on Prepaid Orders
QTY :
-
1
+
Short Description
SBT Instruments Borosilicate Glass 5pcs Petri Dishes Set
150mm Diameter
for Microbiology Experiments
150mm Diameter
for Microbiology Experiments
Country of origin: India
Specifications
- Brand: SBT Instruments
- Material : Borosilicate Glass
- Diameter : 150mm (6 inches)
- Quantity : 5 Pieces
- Type : Reusable Glass Petri Dish
- Color : Transparent
Description
The SBT Instruments Borosilicate Glass Petri Dishes Set is made for reliable and precise microbiological and scientific applications. Each dish is designed from premium borosilicate glass, ensuring excellent thermal resistance, chemical durability, and clarity. With a 150mm diameter, these Petri dishes are ideal for culturing microorganisms, growing bacteria or observing fungal growth in school, college, and professional research laboratories. Reusable and easy to sterilize, they gives a dependable option for consistent experimental results.
Features
:- Made from Borosilicate Glass : High thermal and chemical resistance.
- Large 150mm Diameter : Provides ample surface area for cultures.
- Reusable & Easy to Clean : Autoclavable for long-term laboratory use.
- Transparent & Durable : Ensures clear visibility during observation.
Applications
:- Microbiology and bacteriology culture experiments.
- Used in pharmaceutical, clinical, and food research labs.
- Ideal for observation and sample testing in education and R&D.

Select attribute